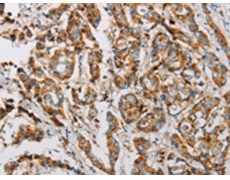
一抗

中文名稱: 兔抗IFITM3多克隆抗體
技術規(guī)格
|
Background: |
The protein encoded by this gene is an interferon-induced membrane protein that helps confer immunity to influenza A H1N1 virus, West Nile virus, and dengue virus. Two transcript variants, only one of them protein-coding, have been found for this gene. Another variant encoding an N-terminally truncated isoform has been reported, but the full-length nature of this variant has not been determined. |
|
Applications: |
ELISA, WB, IHC |
|
Name of antibody: |
IFITM3 |
|
Immunogen: |
Fusion protein of human IFITM3 |
|
Full name: |
interferon induced transmembrane protein 3 |
|
Synonyms: |
1-8U; IP15; DSPA2b |
|
SwissProt: |
Q01628 |
|
ELISA Recommended dilution: |
2000-10000 |
|
IHC positive control: |
Human breast cancer and human esophagus cancer |
|
IHC Recommend dilution: |
25-100 |
|
WB Predicted band size: |
15 kDa |
|
WB Positive control: |
Hela, hepg2 and A375 cells |
|
WB Recommended dilution: |
1000-5000 |


 購物車
購物車 幫助
幫助
 021-54845833/15800441009
021-54845833/15800441009